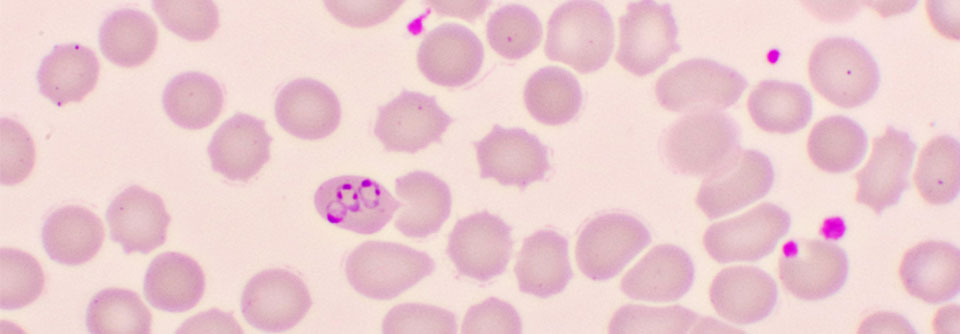

Malaria: Tropenkrankheit im Wandel Stechmücken passen sich an, Plasmodien werden resistent, Schnelltests versagen
 Warum breitet sich Malaria trotz etablierter Präventionsprogramme weiter aus? Resistente Plasmodien, urbanisierte Stechmücken und versagende Tests verschärfen die Situation.
© PixieMe – stock.adobe.com
Warum breitet sich Malaria trotz etablierter Präventionsprogramme weiter aus? Resistente Plasmodien, urbanisierte Stechmücken und versagende Tests verschärfen die Situation.
© PixieMe – stock.adobe.com
Mit Anopheles stephensi macht sich ein Überträger der urbanen Malaria in Afrika breit. Zugleich erschweren Resistenzen gegen Artemisinin und Insektizide die effektive Kontrolle von Erregern und Vektoren. Doch es gibt auch erfreuliche Entwicklungen.
Malaria bleibt eines der größten gesundheitlichen Probleme weltweit. Zwar konnten die Todesfälle durch die Tropenkrankheit seit der Jahrtausendwende deutlich gesenkt werden und laut dem World Malaria Report der WHO gelten inzwischen 44 Länder der Erde als malariafrei. Aber die Zahl der Malariafälle ist 2023 weltweit auf 263 Mio. angestiegen (2022: 252 Mio.). Der Report zeigt auch, dass zwei Drittel der Fälle auf nur elf Länder des afrikanischen Kontinents entfallen. Etwa die Hälfte der Todesfälle betrifft allein Nigeria, die Demokratische Republik Kongo, Niger und Tansania, worauf Dr. Sophie Schneitler vom Institut für Medizinische Mikrobiologie und Hygiene an der Universität des Saarlandes in Homburg hinwies.
Für Surveillance- und Präventionsprogramme ist es entscheidend zu wissen, welche Überträgermücke wo aktiv ist. Nur dann kann man effektiv gegen den Vektor vorgehen, beschrieb Dr. Schneitler. Denn die einzelnen Anopheles-Spezies würden sich deutlich in ihrer Lebensdauer und der damit einhergehenden Vollendung des parasitären Lebenszyklus in der Mücke, ihren Präferenzen zum aquatischen Habitat und dem auf den Menschen bezogenen Stichverhalten unterscheiden.
Mit Anopheles stephensi wurde vor gut zehn Jahren vom indischen Subkontinent ein neuer Vektor nach Afrika eingeschleppt. „Diese Mücke zeigt ein völlig anderes Muster als die übrigen Malariaüberträger“, so die Referentin. „Sie ist der Hauptvektor der urbanen Malaria.“ A. stephensi ist das ganze Jahr über aktiv und brütet auch in kleinen, mit Brackwasser gefüllten Gefäßen, wie es sie in Städten und Siedlungen zuhauf gibt. Die Mücke ist trockenresistent und hitzetolerant und sticht bevorzugt den Menschen.
Nicht nur hinsichtlich ihrer Lebensweise hat sich A. stephensi an den Menschen angepasst wie keine zweite der 400 Anopheles-Spezies, sie ist auch in hohem Maße gegen die gängigen Insektizide und Repellenzien resistent. Die WHO hat entsprechend reagiert und empfiehlt mittlerweile, Bettnetze mit zwei Wirkstoffen statt mit nur Pyrethroid zu imprägnieren.
Es gibt noch weitere Resistenzprobleme, insbesondere in Ostafrika. In den vergangenen Jahren sind dort neue Genpolymorphismen aufgetreten, die den Plasmodien eine partielle oder auch totale Unempfindlichkeit gegenüber Artemisinin, einem der wichtigsten Therapeutika bei Malaria, vermitteln. In Eritrea und Äthiopien weisen die Erreger zunehmend eine Artemisininresistenz zusammen mit einer Deletion im pfhrp2/3*-Gen auf. Damit fehlt das Antigen, das die meisten der gängigen Schnelltests nachweisen. In der Folge führt die Mutation also dazu, dass die Tests nicht funktionieren, ordnete Dr. Schneitler die Bedeutung dieses Sachverhalts ein. Erstmals festgestellt habe man dieses Problem im Jahr 2010 in Peru. Mittlerweile tritt die Deletion in weiten Teilen Südamerikas, Afrikas, Indiens und Asiens in relevantem Umfang auf.
Ungemach droht auch durch neue Zoonosen und neue Vektoren. So sind die Infektionszahlen für Plasmodium knowlesi laut dem WHO-Bericht im Jahr 2023 um 18,9 % auf 3.290 Infizierte gestiegen. Das Geschehen ist derzeit mit 87,4 % der Fälle nahezu auf Malaysia begrenzt. „Für die Zukunft gehe ich aber davon aus, dass wir mehr Fälle von Plasmodium knowlesi in anderen Gebieten sehen werden.“
Es gibt kleine Lichtblicke: Seit November 2024 steht mit Artesunat ein in Deutschland zugelassenes Medikament bei Malaria zur Verfügung. Allerdings ist das Artemisininderivat mit einem Packungspreis von 3.200 Euro vergleichsweise teuer, erklärte die Referntin. Da komme man schnell auf Therapiekosten von 10.000 Euro und mehr.
Mittlerweile stehen auch zwei Impfstoffe für den Einsatz in Hochendemiegebieten zur Verfügung. Allerdings bleibe abzuwarten, ob als Folge der Vakzinierung in der Kindheit und der damit verbundenen fehlenden Teilimmunität das Risiko für schwere Malariaepisoden im Erwachsenenalter womöglich steigt. In einer solchen Situation könnte eine passive Immunisierung mit Malariaantikörpern eine Lösung bieten, gab die Referentin einen Ausblick.
*Plasmodium falciparum histidine-rich protein 2/3
Quelle: 26. Forum Reisen und Gesundheit